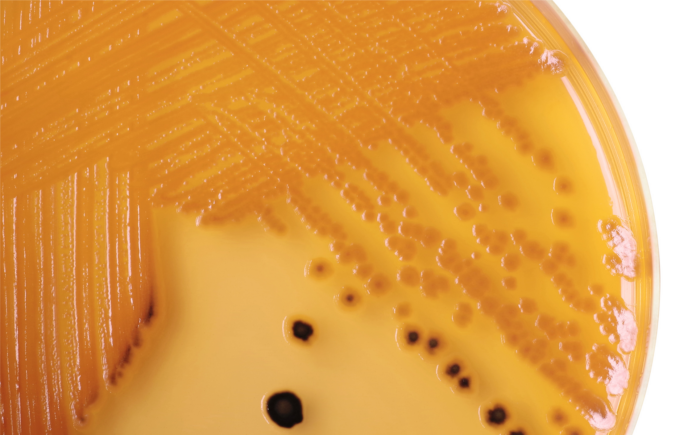
Salmonella

På mindre end en måned er mindst 40 danskere blevet smittet med samme type salmonella. DTU Fødevareinstituttet, Fødevarestyrelsen og Statens Serum Institut efterforsker i øjeblikket udbruddet, og der registreres fortsat nye patienter. Myndighederne mistænker hakket kød for at være smittekilden.
Siden midten af marts har 40 patienter været registreret syge med den samme type salmonella. Det drejer sig om 24 mænd og 16 kvinder i alderen 0-83 år. De første undersøgelser viser, at patienterne ikke har været ude at rejse, ikke har spist på de samme restauranter og ikke har deltaget i nogle fælles arrangementer. Da patienterne bor i hele landet, tyder det derfor på, at det er en fødevare, der har været solgt i supermarkeder landet over.
– Vi arbejder på at finde ud af, hvad der er skyld i udbruddet. Foreløbige undersøgelser peger på, at smittekilden kunne være hakket kød solgt i supermarkeder, udtaler epidemiolog Luise Müller, Statens Serum Institut.
Annette Perge fra Fødevarestyrelsen uddyber:
– Selvom vi endnu ikke ved med sikkerhed, hvad der har gjort folk syge med salmonella, vil vi gerne have at forbrugerne er ekstra opmærksomme på den gode køkkenhygiejne. Det er vigtigt, at man gennemsteger hakket kød, holder det spiseklare adskilt fra det rå kød og lader være med at smage på det rå kød, siger hun.
Sådan kan du undgå at blive smittet med salmonella
- Vask hænder, inden du går i gang med at lave mad og efter at have rørt ved råt kød
- Undlad at smage på råt kød fx frikadellefarsen
- Hold det rå kød adskilt fra den spiseklare mad fx salat
- Gennemsteg/gennemkog hakket kød